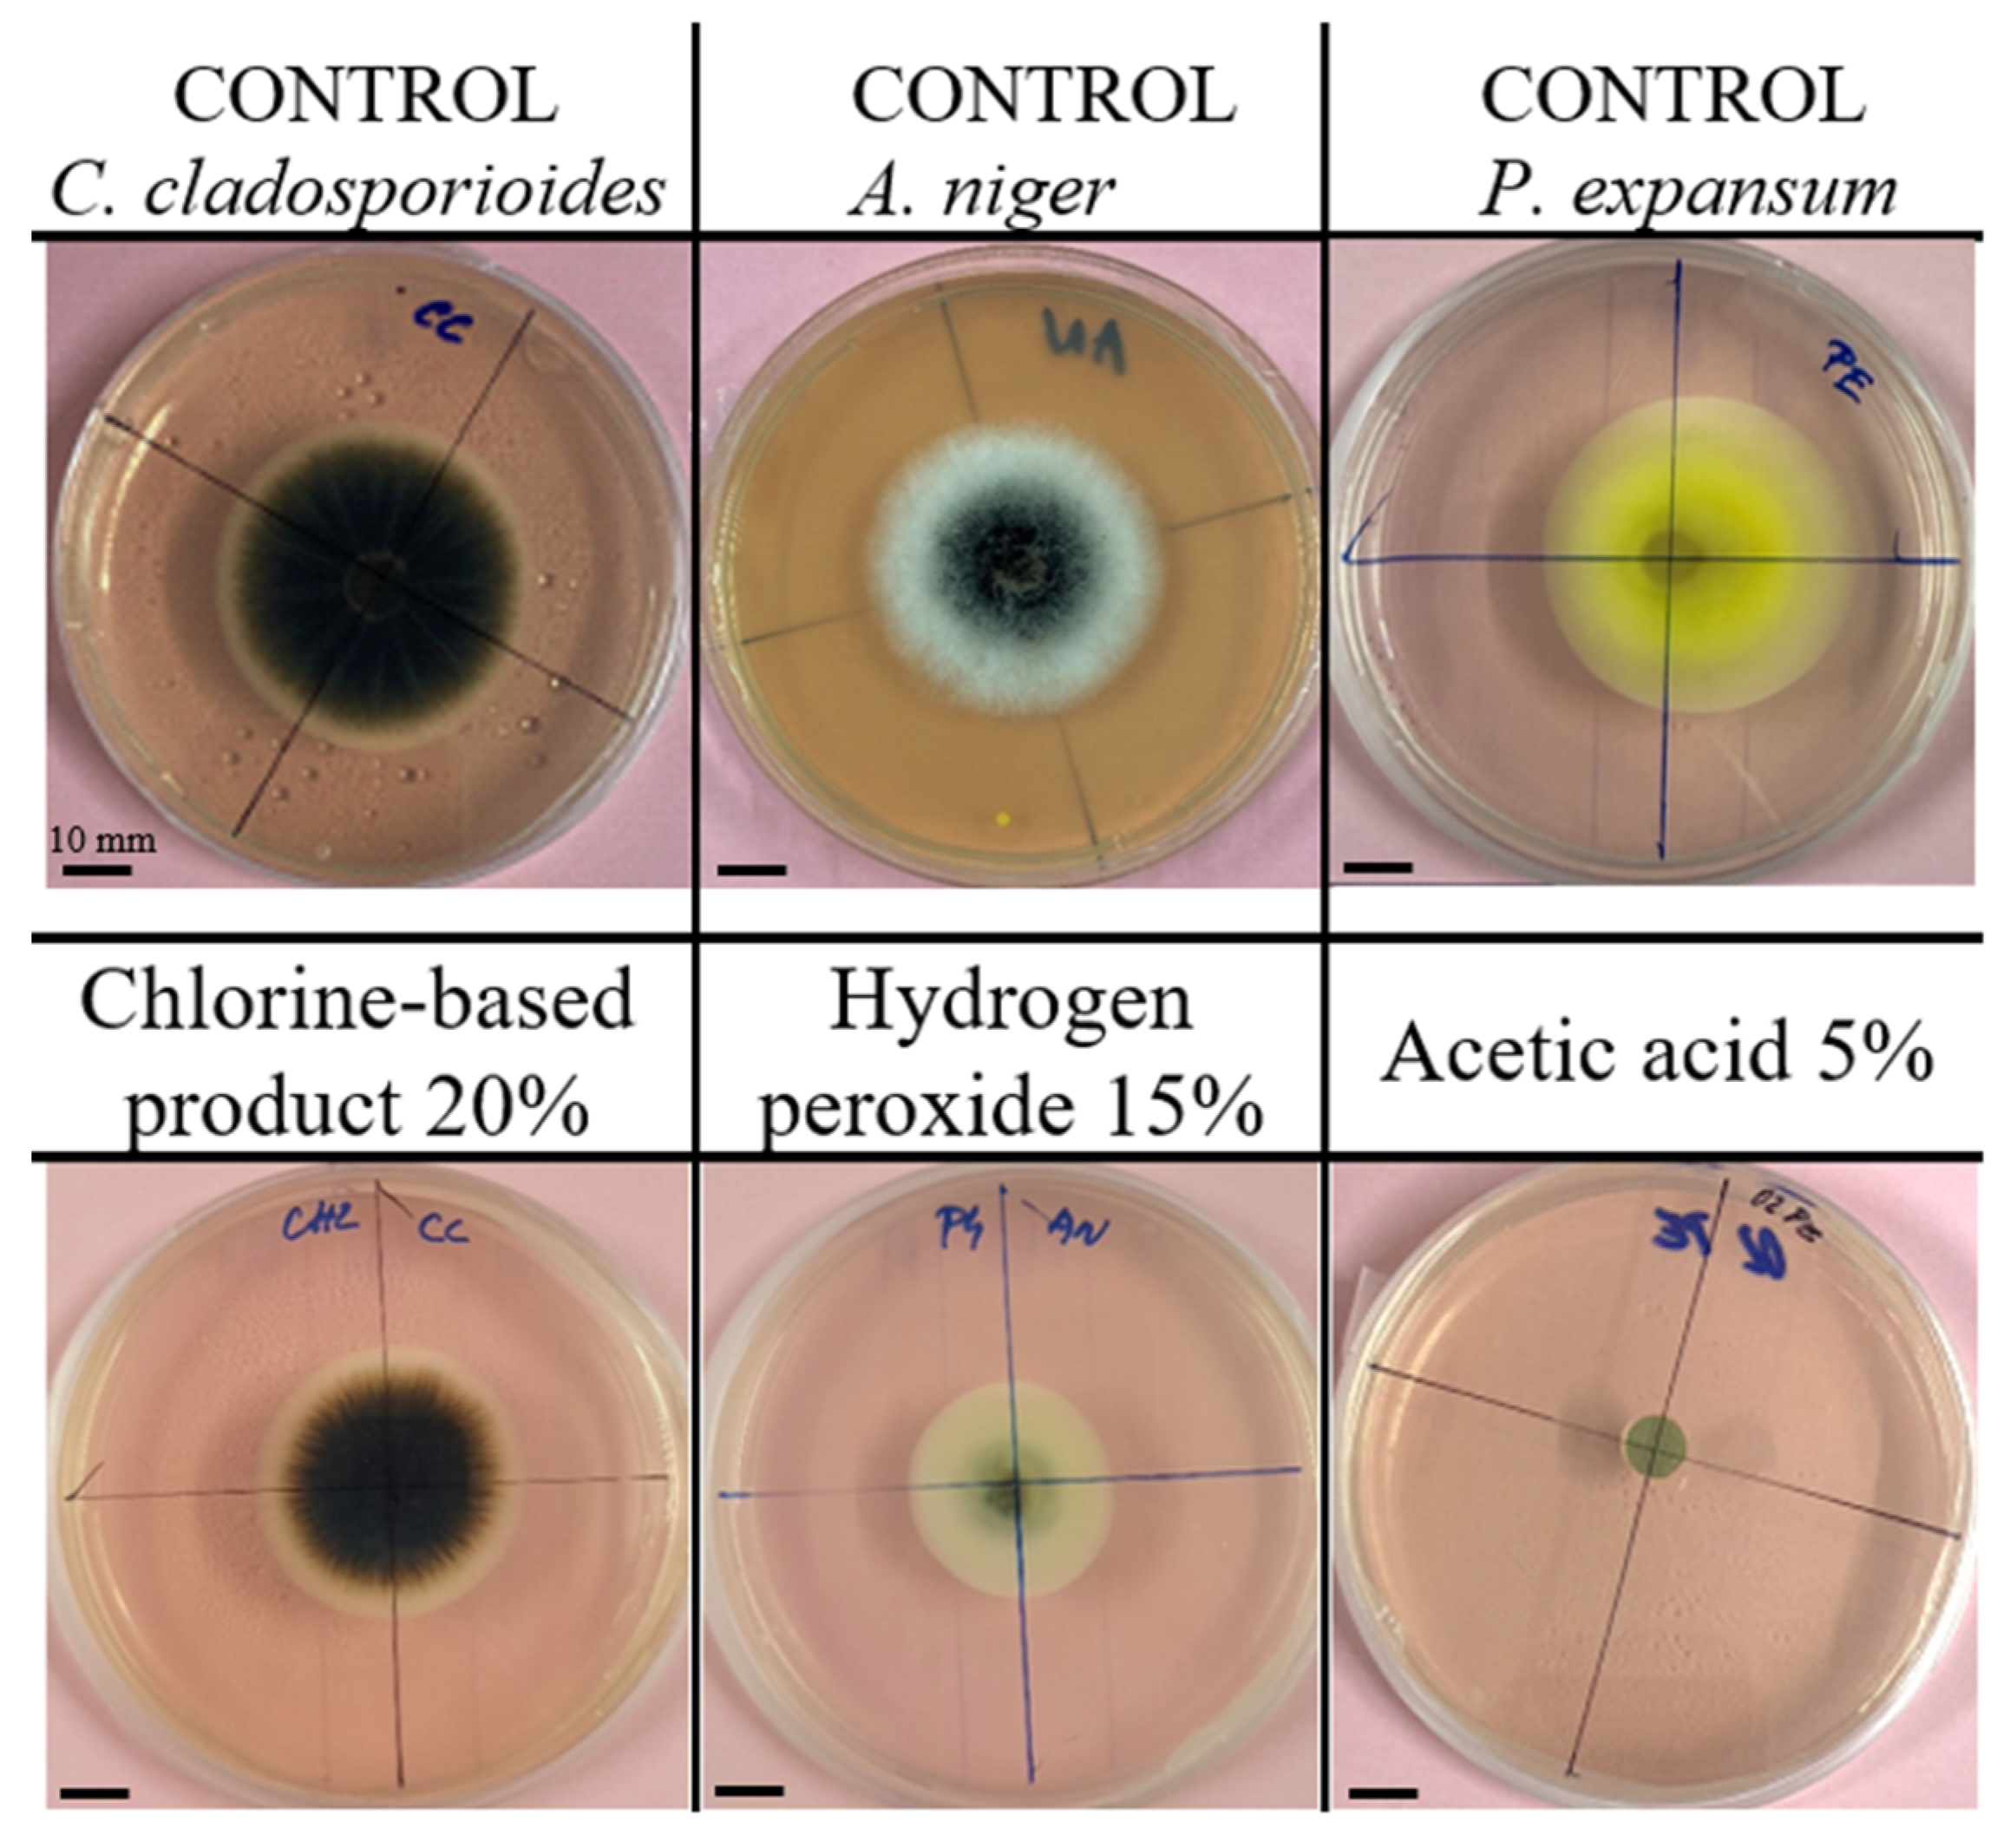
Microbiolres 16 00182 g001

Inhibitory Effects of Selected Chemical Substances on the Growth of Filamentous Fungi Occurring in Cellar Management
Abstract
1. Introduction
2. Materials and Methods
2.1. Microorganisms
2.2. Culture Media
2.3. In Vitro Inhibition Test
2.4. Inhibitors
2.5. Statistical Analysis
3. Results and Discussion
3.1. Representative Images of Fungal Growth
3.2. Sulphur Dioxide SO2–Solution NH4HSO3
3.3. Hydrogen Peroxide—H2O2
3.4. Copper(II) Sulphate Pentahydrate—CuSO4·5H2O
3.5. Chlorine-Based Products


3.6. Chlorine-Free Product (FUNGISAN)
3.7. Ethanol—C2H5OH
3.8. Acetic Acid—CH3COOH
3.9. Summary
4. Conclusions
Author Contributions
Funding
Institutional Review Board Statement
Informed Consent Statement
Data Availability Statement
Conflicts of Interest
Abbreviations
| CCM | Czech Collection of Microorganisms |
| CH3COOH | acetic acid |
| C2H5OH | ethanol |
| ClO2 | chlorine dioxide |
| CuSO4·5H2O | copper(II) sulphate pentahydrate |
| e.g., | exempli gratia |
| NaClO | sodium hypochlorite |
| NH4HSO3 | ammonium bisulphate |
| OIT | 2-octyl-2H-isothiazol-3-one |
| LSD | least significant difference |
| PAA | peracetic acid |
| ROS | reactive oxygen species |
References
- Le Montagner, P.; Etourneau, L.; Ballestra, P.; Dols-Lafargue, M.; Albertin, W.; Maupeu, J.; Moine, V.; Renouf, V.; Masneuf-Pomarède, I. Critical areas for Brettanomyces bruxellensis contamination and biofilm formation in the cellar: On the origin of wine spoilage. OENO One 2024, 58. [Google Scholar] [CrossRef]
- Liu, D.; Zhang, P.; Chen, D.; Howell, K. From the vineyard to the winery: How microbial ecology drives regional distinctiveness of wine. Front. Microbiol. 2019, 10, 2679. [Google Scholar] [CrossRef]
- Aires, C.; Maioto, R.; Inês, A.; Dias, A.A.; Rodrigues, P.; Egas, C.; Sampaio, A. Microbiome and Microbiota Within Wineries: A Review. Microorganisms 2025, 13, 538. [Google Scholar] [CrossRef]
- Abdo, H.; Catacchio, C.R.; Ventura, M.; D’Addabbo, P.; Alexandre, H.; Guilloux-Bénatier, M.; Rousseaux, S. The establishment of a fungal consortium in a new winery. Sci. Rep. 2020, 10, 7962. [Google Scholar] [CrossRef]
- Ortiz-Villeda, B.; Lobos, O.; Aguilar-Zuniga, K.; Carrasco-Sánchez, V. Ochratoxins in wines: A review of their occurrence in the last decade, toxicity, and exposure risk in humans. Toxins 2021, 13, 478. [Google Scholar] [CrossRef]
- Wu, H.; Wong, J.W.C. Mechanisms of indoor mold survival under moisture dynamics, a special water treatment approach within the indoor context. Chemosphere 2022, 302, 134748. [Google Scholar] [CrossRef]
- Stadler, E.; Fischer, U. Sanitization of oak barrels for wine—A review. J. Agric. Food Chem. 2020, 68, 5283–5295. [Google Scholar] [CrossRef] [PubMed]
- Magyar, D.; Kállai, Z.; Sipiczki, M.; Dobolyi, C.; Sebők, F.; Beregszászi, T.; Bihari, Z.; Kredics, L.; Oros, G. Survey of viable airborne fungi in wine cellars of Tokaj, Hungary. Aerobiologia 2018, 34, 171–185. [Google Scholar] [CrossRef]
- Caillaud, D.; Keirsbulck, M.; Leger, C.; Leynaert, B.; of the Outdoor Mould ANSES Working Group. Outdoor mold and respiratory health: State of science of epidemiological studies. J. Allergy Clin. Immunol. Pract. 2022, 10, 768–784.e763. [Google Scholar] [CrossRef] [PubMed]
- Hurraß, J.; Heinzow, B.; Aurbach, U.; Bergmann, K.-C.; Bufe, A.; Buzina, W.; Cornely, O.A.; Engelhart, S.; Fischer, G.; Gabrio, T. Medical diagnostics for indoor mold exposure. Int. J. Hyg. Environ. Health 2017, 220, 305–328. [Google Scholar] [CrossRef]
- La Placa, L.; Tsitsigiannis, D.; Camardo Leggieri, M.; Battilani, P. From grapes to wine: Impact of the vinification process on ochratoxin A contamination. Foods 2023, 12, 260. [Google Scholar] [CrossRef]
- Zjalic, S.; Markov, K.; Loncar, J.; Jakopovic, Z.; Beccaccioli, M.; Reverberi, M. Biocontrol of occurrence Ochratoxin A in wine: A review. Toxins 2024, 16, 277. [Google Scholar] [CrossRef]
- Cosme, F.; Filipe-Ribeiro, L.; Nunes, F.M. Wine stabilisation: An overview of defects and treatments. Chem. Biochem. Winemak. Wine Stab. Aging 2021, 21, 175–204. [Google Scholar]
- Considine, J.A.; Frankish, E.J. Chapter 6—Microbiology and methods. In A Complete Guide to Quality in Small-Scale Wine Making, 2nd ed.; Considine, J.A., Frankish, E.J., Eds.; Academic Press: Cambridge, MA, USA, 2023; pp. 93–109. [Google Scholar]
- Marx, C.; Oberholster, A. Optimizing concentrations and contact times of cleaning and sanitizing agents for inactivating winery spoilage microorganisms. In Proceedings of the BIO Web of Conferences; EDP Science: Les Ulis, France, 2019; p. 02009. [Google Scholar]
- Marx, C.J. Winery Cleaning and Sanitization: Optimized Chemistries for Managing Fermentation Soils and the Sulfur Dioxide Fumigation of Winery Cooperage; University of California, Davis: Davis, CA, USA, 2021. [Google Scholar]
- Freitag, A.; Cluff, M.; Pretorius, W.; Bothma, C.; Hugo, A.; Hugo, C. Chemical, Microbial, and Sensory Effects of Natural Preservatives as Sulfur Dioxide Replacers in Boerewors. J. Food Process. Preserv. 2024, 2024, 4336909. [Google Scholar] [CrossRef]
- Damiano, C.; Intrieri, D.; Sonzini, P.; Rizzato, S.; Di Natale, C.; Paolesse, R.; Gallo, E. Nickel (0) Complexes as Promising Chemosensors for Detecting the “Cork Taint” in Wine. Eur. J. Inorg. Chem. 2022, 2022, e202101013. [Google Scholar] [CrossRef]
- Baker, J.; Rana, Y.S.; Chen, L.; Beary, M.A.; Balasubramaniam, V.; Snyder, A.B. Superheated steam can rapidly inactivate bacteria, but manual operation of commercial units resulted in limited efficacy during dry surface sanitization. J. Food Prot. 2025, 88, 100461. [Google Scholar] [CrossRef]
- Oztoprak, N.; Kizilates, F.; Percin, D. Comparison of steam technology and a two-step cleaning (water/detergent) and disinfecting (1,000 resp. 5,000 ppm hypochlorite) method using microfiber cloth for environmental control of multidrug-resistant organisms in an intensive care unit. GMS Hyg. Infect. Control 2019, 14, Doc15. [Google Scholar]
- Breniaux, M.; Renault, P.; Meunier, F.; Ghidossi, R. Study of high power ultrasound for oak wood barrel regeneration: Impact on wood properties and sanitation effect. Beverages 2019, 5, 10. [Google Scholar] [CrossRef]
- Guzzon, R.; Bernard, M.; Barnaba, C.; Bertoldi, D.; Pixner, K.; Larcher, R. The impact of different barrel sanitation approaches on the spoilage microflora and phenols composition of wine. J. Food Sci. Technol. 2017, 54, 810–821. [Google Scholar] [CrossRef] [PubMed]
- Epelle, E.I.; Macfarlane, A.; Cusack, M.; Burns, A.; Okolie, J.A.; Mackay, W.; Rateb, M.; Yaseen, M. Ozone application in different industries: A review of recent developments. Chem. Eng. J. 2023, 454, 140188. [Google Scholar] [CrossRef]
- Mousavi, B.; Hedayati, M.T.; Hedayati, N.; Ilkit, M.; Syedmousavi, S. Aspergillus species in indoor environments and their possible occupational and public health hazards. Curr. Med. Mycol. 2016, 2, 36. [Google Scholar] [CrossRef]
- Chen, L.; Ingham, B.; Ingham, S. Survival of Penicillium expansum and patulin production on stored apples after wash treatments. J. Food Sci. 2004, 69, C669–C675. [Google Scholar] [CrossRef]
- Segers, F.J.; Meijer, M.; Houbraken, J.; Samson, R.A.; Wösten, H.A.; Dijksterhuis, J. Xerotolerant Cladosporium sphaerospermum are predominant on indoor surfaces compared to other Cladosporium species. PLoS ONE 2015, 10, e0145415. [Google Scholar] [CrossRef]
- Khalaf, E.; Mohammadi, M.; Sulistiyani, S.; Ramirez, A.; Al-Attabi, A.; Almulla, A.; Asban, P.; Farhadi, M.; Derikondi, M. Effects of sulfur dioxide inhalation on human health: A review. Rev. Environ. Health 2022, 39, 331–337. [Google Scholar] [CrossRef]
- Cai, Y.; Zhao, Y.; Ma, X.; Zhou, K.; Chen, Y. Influence of environmental factors on atmospheric corrosion in dynamic environment. Corros. Sci. 2018, 137, 163–175. [Google Scholar] [CrossRef]
- Zhao, X.; Zhou, J.; Tian, R.; Liu, Y. Microbial volatile organic compounds: Antifungal mechanisms, applications, and challenges. Front. Microbiol. 2022, 13, 922450. [Google Scholar] [CrossRef]
- Wang, T.; Yang, Y.; Liu, M.; Liu, H.; Liu, H.; Xia, Y.; Xun, L. Elemental sulfur inhibits yeast growth via producing toxic sulfide and causing disulfide stress. Antioxidants 2022, 11, 576. [Google Scholar] [CrossRef]
- Jiang, C.; Shi, J.; Chen, X.; Liu, Y. Effect of sulfur dioxide and ethanol concentration on fungal profile and ochratoxin a production by Aspergillus carbonarius during wine making. Food Control 2015, 47, 656–663. [Google Scholar] [CrossRef]
- Davidson, P.M.; Sofos, J.N.; Branen, A.L. Antimicrobials in Food; CRC press: Boca Raton, FL, USA, 2005. [Google Scholar]
- Kazemi, A.; Sedaghat, E.; Fani, S.R.; Moradi, M.; Nadi, M. Effect of sulfur on toxigenic Aspergillus flavus in vitro. J. Nuts 2023, 14, 273–282. [Google Scholar] [CrossRef]
- Everitt, E.L.; Sullivan, M. The fungistatic and fungicidal action of certain organic sulphur compounds. J. Wash. Acad. Sci. 1940, 30, 125–131. [Google Scholar]
- Muhialdin, B.J.; Hassan, Z.; Sadon, S.K. Biopreservation of food by lactic acid bacteria against spoilage fungi. Ann. Food Sci. Technol. 2011, 12, 45–57. [Google Scholar]
- Wiberth, C.-C.; Casandra, A.-Z.C.; Zhiliang, F.; Gabriela, H. Oxidative enzymes activity and hydrogen peroxide production in white-rot fungi and soil-borne micromycetes co-cultures. Ann. Microbiol. 2019, 69, 171–181. [Google Scholar] [CrossRef]
- Petigara, B.R.; Blough, N.V.; Mignerey, A.C. Mechanisms of hydrogen peroxide decomposition in soils. Environ. Sci. Technol. 2002, 36, 639–645. [Google Scholar] [CrossRef]
- Mosquera-Romero, S.; Prévoteau, A.; Vanwonterghem, I.; Arends, J.B.; Dominguez, L.; Rousseau, D.P.; Rabaey, K. Hydrogen peroxide in bioelectrochemical systems negatively affects microbial current generation. J. Appl. Electrochem. 2021, 51, 1463–1478. [Google Scholar] [CrossRef]
- Sharaf-Eldin, M.A.; Geösel, A. Efficacy of hydrogen peroxide on postharvest quality of white button mushroom. Egypt. J. Hort 2016, 43, 1–17. [Google Scholar]
- Cerioni, L.; Rapisarda, V.A.; Hilal, M.; Prado, F.E.; Rodriguez-Montelongo, L. Synergistic antifungal activity of sodium hypochlorite, hydrogen peroxide, and cupric sulfate against Penicillium digitatum. J. Food Prot. 2009, 72, 1660–1665. [Google Scholar] [CrossRef]
- Martin, H.; Maris, P. Synergism between hydrogen peroxide and seventeen acids against five agri-food-borne fungi and one yeast strain. J. Appl. Microbiol. 2012, 113, 1451–1460. [Google Scholar] [CrossRef]
- Robinson, J.R.; Isikhuemhen, O.S.; Anike, F.N. Fungal–metal interactions: A review of toxicity and homeostasis. J. Fungi 2021, 7, 225. [Google Scholar] [CrossRef]
- Araujo, R.; Gonçalves Rodrigues, A.; Pina-Vaz, C. Susceptibility pattern among pathogenic species of Aspergillus to physical and chemical treatments. Med. Mycol. 2006, 44, 439–443. [Google Scholar] [CrossRef]
- Cerioni, L.; de los Ángeles Lazarte, M.; Villegas, J.M.; Rodríguez-Montelongo, L.; Volentini, S.I. Inhibition of Penicillium expansum by an oxidative treatment. Food Microbiol. 2013, 33, 298–301. [Google Scholar] [CrossRef]
- Henry, P.; Halbus, A.F.; Athab, Z.H.; Paunov, V.N. Enhanced antimould action of surface modified copper oxide nanoparticles with phenylboronic acid surface functionality. Biomimetics 2021, 6, 19. [Google Scholar] [CrossRef]
- Pařil, P.; Baar, J.; Čermák, P.; Rademacher, P.; Prucek, R.; Sivera, M.; Panáček, A. Antifungal effects of copper and silver nanoparticles against white and brown-rot fungi. J. Mater. Sci. 2017, 52, 2720–2729. [Google Scholar] [CrossRef]
- Zatkalíková, V.; Markovičová, L. The effect of long-term exposure in mixed sulfuric acid and copper sulfate solution on corrosion behavior of austenitic stainless steels. Proc. J. Phys. Conf. Ser. 2024, 2712, 012003. [Google Scholar] [CrossRef]
- Xu, X.; Cao, R.; Li, K.; Wan, Q.; Wu, G.; Lin, Y.; Huang, T.; Wen, G. The protective role and mechanism of melanin for Aspergillus niger and Aspergillus flavus against chlorine-based disinfectants. Water Res. 2022, 223, 119039. [Google Scholar] [CrossRef]
- Wang, Y.; Wu, G.; Wan, Q.; Wang, J.; Wen, G. Comparisons on the evaluation methods of chlorine resistance fungi in drinking water. Environ. Res. 2025, 278, 121650. [Google Scholar] [CrossRef]
- Kasatkina, E.A.; Shumilov, O.I.; Kirtsideli, I.Y.; Makarov, D.V. Hormesis and Low Toxic Effects of Three Lanthanides in Microfungi Isolated from Rare Earth Mining Waste in Northwestern Russia. Toxics 2023, 11, 1010. [Google Scholar] [CrossRef]
- Garzon, C.D.; Flores, F.J. Hormesis: Biphasic dose-responses to fungicides in plant pathogens and their potential threat to agriculture. In Fungicides–Showcases of Integrated Plant Disease Management from Around the World; InTech: London, UK, 2013; pp. 311–328. [Google Scholar]
- Jiang, Y.; Qiao, Y.; Jin, R.; Jia, M.; Liu, J.; He, Z.; Liu, Z. Application of chlorine dioxide and its disinfection mechanism. Arch. Microbiol. 2024, 206, 400. [Google Scholar] [CrossRef]
- Đurđević-Milošević, D.; Petrović, A.; Elez, J.; Kalaba, V.; Gagula, G. Environmental protection through the rational use of sodium hypochlorite as a fungicide. In Proceedings of the XV International Mineral Processing and Recycling Conference, IMPRC, Belgrade, Serbia, 17–19 May 2023; pp. 542–547. [Google Scholar]
- Reynolds, K.; Boone, S.; Bright, K.; Gerba, C. Efficacy of sodium hypochlorite disinfectant on the viability and allergenic properties of household mold. J. Allergy Clin. Immunol. 2004, 113, S180. [Google Scholar] [CrossRef]
- Visconti, V.; Coton, E.; Rigalma, K.; Dantigny, P. Effects of disinfectants on inactivation of mold spores relevant to the food industry: A review. Fungal Biol. Rev. 2021, 38, 44–66. [Google Scholar] [CrossRef]
- Visconti, V.; Rigalma, K.; Coton, E.; Dantigny, P. Impact of the physiological state of fungal spores on their inactivation by active chlorine and hydrogen peroxide. Food Microbiol. 2021, 100, 103850. [Google Scholar] [CrossRef]
- Reeder, N.L.; Xu, J.; Youngquist, R.; Schwartz, J.; Rust, R.; Saunders, C. The antifungal mechanism of action of zinc pyrithione. Br. J. Dermatol. 2011, 165, 9–12. [Google Scholar] [CrossRef]
- Silva, V.; Silva, C.; Soares, P.; Garrido, E.M.; Borges, F.; Garrido, J. Isothiazolinone biocides: Chemistry, biological, and toxicity profiles. Molecules 2020, 25, 991. [Google Scholar] [CrossRef]
- Heri, W.; Pfister, F.; Carroll, B.; Parshley, T.; Nabors, J.B. Production, development, and registration of triazine herbicides. Triazine Herbic. 2008, 50, 584. [Google Scholar]
- Li, W.; Chen, M.; Li, Y.; Sun, J.; Liu, Y.; Guo, H. Improving mildew resistance of soy meal by nano-Ag/TiO2, zinc pyrithione and 4-cumylphenol. Polymers 2020, 12, 169. [Google Scholar] [CrossRef]
- Dao, T.; Dantigny, P. Control of food spoilage fungi by ethanol. Food Control 2011, 22, 360–368. [Google Scholar] [CrossRef]
- Palombo, E.A. Ethanol treatment does not inactivate spore-forming bacteria–A cautionary note about the safe transport of bacteria prior to identification by MALDI-TOF MS. J. Microbiol. Methods 2020, 172, 105893. [Google Scholar] [CrossRef]
- Oh, E.; Shin, H.; Han, S.; Do, S.J.; Shin, Y.; Pi, J.H.; Kim, Y.; Ko, D.-H.; Lee, K.H.; Choi, H.-J. Enhanced biocidal efficacy of alcohol based disinfectants with salt additives. Sci. Rep. 2025, 15, 3950. [Google Scholar] [CrossRef]
- Sequeira, S.O.; Phillips, A.J.; Cabrita, E.J.; Macedo, M.F. Ethanol as an antifungal treatment for paper: Short-term and long-term effects. Stud. Conserv. 2017, 62, 33–42. [Google Scholar] [CrossRef]
- Dantigny, P.; Guilmart, A.; Radoi, F.; Bensoussan, M.; Zwietering, M. Modelling the effect of ethanol on growth rate of food spoilage moulds. Int. J. Food Microbiol. 2005, 98, 261–269. [Google Scholar] [CrossRef]
- Khalifa, S.A.; El-Shabasy, R.M.; Tahir, H.E.; Abo-Atya, D.M.; Saeed, A.; Abolibda, T.; Guo, Z.; Zou, X.; Zhang, D.; Du, M. Vinegar, the beneficial food additive: Production, safety, possibilities, and applications from ancient to modern times. Food Funct. 2024, 15, 10262–10282. [Google Scholar] [CrossRef]
- Román-Camacho, J.J.; García-García, I.; Santos-Dueñas, I.M.; García-Martínez, T.; Mauricio, J.C. Latest trends in industrial vinegar production and the role of acetic acid bacteria: Classification, metabolism, and applications—A comprehensive review. Foods 2023, 12, 3705. [Google Scholar] [CrossRef]
- Lourenço, A.; Pedro, N.A.; Salazar, S.B.; Mira, N.P. Effect of acetic acid and lactic acid at low pH in growth and azole resistance of Candida albicans and Candida glabrata. Front. Microbiol. 2019, 9, 3265. [Google Scholar] [CrossRef]
- Zinn, M.-K.; Bockmühl, D. Did granny know best? Evaluating the antibacterial, antifungal and antiviral efficacy of acetic acid for home care procedures. BMC Microbiol. 2020, 20, 1–9. [Google Scholar] [CrossRef]
- Kuroki, M.; Shiga, Y.; Narukawa-Nara, M.; Arazoe, T.; Kamakura, T. Extremely low concentrations of acetic acid stimulate cell differentiation in rice blast fungus. Iscience 2020, 23, 100786. [Google Scholar] [CrossRef]
- Al-Sawah, I.; Walid, E.; Hazem, J.; Essama, R.; Ashraf, R.; Azab, S.; Fakhry, S.; Mubarak, M.; Ahmed, N.; Nassar, H. Effect of some essential oils, some plant extracts and white vinegar against some plant pathogenic fungi. Sci. J. Fac. Sci. Menoufia Univ. 2024, 28, 71–80. [Google Scholar] [CrossRef]
- Niamat, H.; Imtiaz, A.; Khan, M.A. Efficacy of Different Vinegars as Antifungal Agents Against Aspergillusniger. Lahore Garrison Univ. J. Life Sci. 2019, 3, 140–146. [Google Scholar] [CrossRef]
- Alcano, M.d.J.; Jahn, R.C.; Scherer, C.D.; Wigmann, É.F.; Moraes, V.M.; Garcia, M.V.; Mallmann, C.A.; Copetti, M.V. Susceptibility of Aspergillus spp. to acetic and sorbic acids based on pH and effect of sub-inhibitory doses of sorbic acid on ochratoxin A production. Food Res. Int. 2016, 81, 25–30. [Google Scholar] [CrossRef]
- Qassim, R.A.; Ahmad, S.O. Inhibitory Effect of Acetic Acid on Aspergillus flavus Growth and Kojic Acid and Aflatoxin B1 Production in Stored Corn. Tikrit J. Agric. Sci. 2018, 18, 60–69. [Google Scholar]
- Morgunov, I.G.; Kamzolova, S.V.; Dedyukhina, E.G.; Chistyakova, T.I.; Lunina, J.N.; Mironov, A.A.; Stepanova, N.N.; Shemshura, O.N.; Vainshtein, M.B. Application of organic acids for plant protection against phytopathogens. Appl. Microbiol. Biotechnol. 2017, 101, 921–932. [Google Scholar] [CrossRef]
- Talukdar, A.; Rajaraman, P.V. Investigation of Acetic Acid Effect on Carbon Steel Corrosion in CO2-H2S Medium: Mechanistic Reaction Pathway and Kinetics. ACS Omega 2020, 5, 11378–11388. [Google Scholar] [CrossRef]
- Liu, B.; Huang, B.; Ma, X.; Huang, H.; Zou, C.; Liu, J.; Luo, Q.; Wang, C.; Liang, J. Recent advances in peracetic acid-based advanced oxidation processes for emerging pollutants elimination: A review. J. Environ. Chem. Eng. 2024, 12, 112927. [Google Scholar] [CrossRef]
- Abdelrhim, A.S.; Dawood, M.F.; Galal, A.A. Hydrogen peroxide-mixed compounds and/or microwave radiation as alternative control means against onion seed associated pathogens, Aspergillus niger and Fusarium oxysporum. J. Plant Pathol. 2022, 104, 49–63. [Google Scholar] [CrossRef]
- Hosotani, Y.; Nakamura, N.; Kito, H.; Inatsu, Y. Effectiveness of sodium hypochlorite and peracetic acid for spoilage-causing molds on sweet potato slices. Food Sci. Technol. Res. 2023, 29, 257–267. [Google Scholar] [CrossRef]

| Inhibitors | 1 | 2 | 3 | 4 |
|---|---|---|---|---|
| Sulphur dioxide–solution NH4HSO3 | 4% v/v | 2% v/v | 1% v/v | 0.5% v/v |
| Hydrogen peroxide—H2O2 | 30% w/v | 25% w/v | 20% w/v | 15% w/v |
| Copper(II) sulphate pentahydrate— CuSO4·5H2O | 10% w/v (100 g∙L−1) | 5% w/v (50 g∙L−1) | 2.5% w/v (25 g∙L−1) | 1% w/v (10 g∙L−1) |
| Chlorine-based product Floor and wall cleaner + Cl | 40% w/v (400 g∙L−1) | 20% w/v (200 g∙L−1) | 10% w/v (100 g∙L−1 *) | 1% w/v (10 g∙L−1 *) |
| NaClO-based product—Savo | 50% w/v | 25% w/v | 10% w/v | 1% w/v |
| Chlorine-free product—FungiSAN | 16.7% w/v (1:5) | 10% w/v (1:9 *) | 5% w/v (1:19 *) | 1.9% w/v (1:50) |
| Ethanol—C2H5OH | 96% v/v | 84.4% v/v | 76.8% v/v | 67.2% v/v |
| Acetic acid—CH3COOH | 10% v/v | 5% v/v | 1% v/v | 0.5% v/v |
Disclaimer/Publisher’s Note: The statements, opinions and data contained in all publications are solely those of the individual author(s) and contributor(s) and not of MDPI and/or the editor(s). MDPI and/or the editor(s) disclaim responsibility for any injury to people or property resulting from any ideas, methods, instructions or products referred to in the content. |
© 2025 by the authors. Licensee MDPI, Basel, Switzerland. This article is an open access article distributed under the terms and conditions of the Creative Commons Attribution (CC BY) license (https://creativecommons.org/licenses/by/4.0/).
Share and Cite
Kostelnikova, K.; Heralecka, R.; Krpatova, A.; Matousek, F.; Sochor, J.; Baron, M. Inhibitory Effects of Selected Chemical Substances on the Growth of Filamentous Fungi Occurring in Cellar Management. Microbiol. Res. 2025, 16, 182. https://doi.org/10.3390/microbiolres16080182
Kostelnikova K, Heralecka R, Krpatova A, Matousek F, Sochor J, Baron M. Inhibitory Effects of Selected Chemical Substances on the Growth of Filamentous Fungi Occurring in Cellar Management. Microbiology Research. 2025; 16(8):182. https://doi.org/10.3390/microbiolres16080182
Chicago/Turabian StyleKostelnikova, Karolina, Romana Heralecka, Anna Krpatova, Filip Matousek, Jiri Sochor, and Mojmir Baron. 2025. "Inhibitory Effects of Selected Chemical Substances on the Growth of Filamentous Fungi Occurring in Cellar Management" Microbiology Research 16, no. 8: 182. https://doi.org/10.3390/microbiolres16080182
APA StyleKostelnikova, K., Heralecka, R., Krpatova, A., Matousek, F., Sochor, J., & Baron, M. (2025). Inhibitory Effects of Selected Chemical Substances on the Growth of Filamentous Fungi Occurring in Cellar Management. Microbiology Research, 16(8), 182. https://doi.org/10.3390/microbiolres16080182

